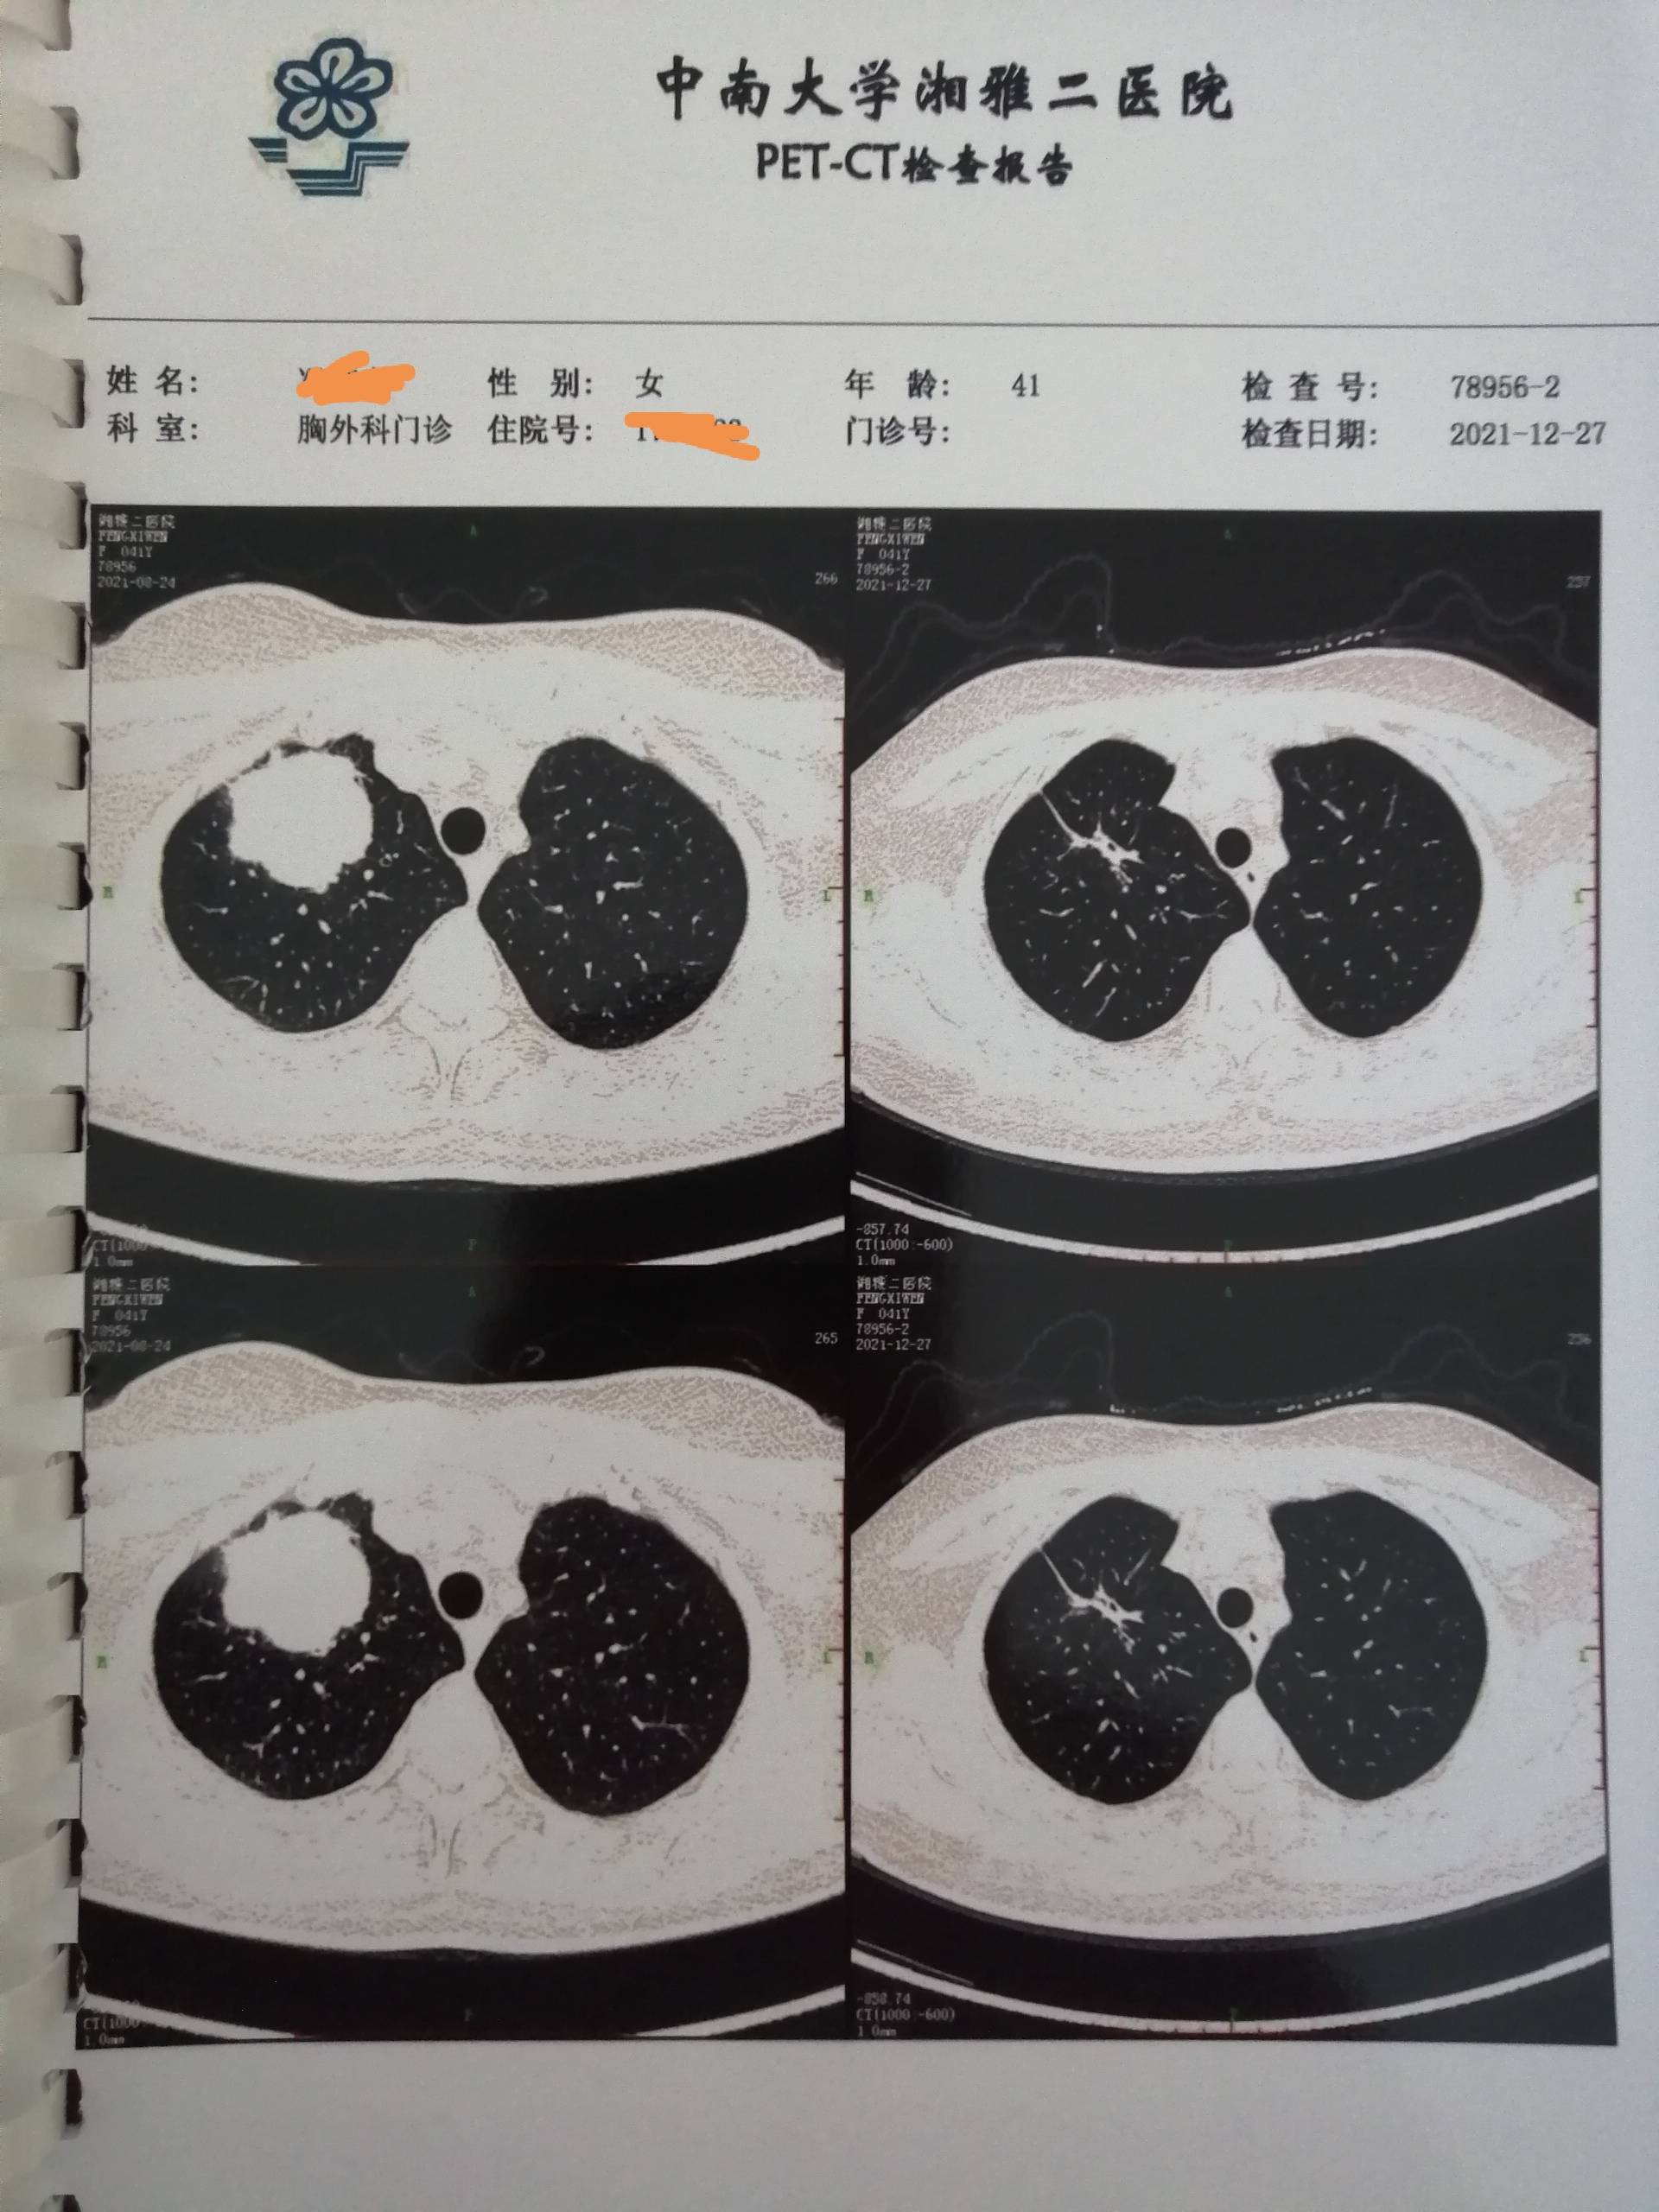
图片

免疫+化疗第四次治疗后PET-CT复查,为手术做准备了!
第三次K药 化疗很顺利,第四次治疗足足等到第35天才来电话,医院床位紧张,没办法。2021年12月27日上午PET-CT,26日冒大雪开车3小时赶到医院对面宾馆对付一晚,27日一早便赶紧进医院排队,好几个上午预约的因大雪天气没能急时赶到。第二天拿到结果立马联系主治医生和胸外科医生,确定元旦后手术,开好住院证安心等入院电话。四次治疗后PET结果很棒,局部病灶只剩条索影了,SUVmax值由20.75降到2.7。肺门及纵膈淋巴结影明显减少缩小,其他见附图。四个月过去了,K药联合化疗,效果显著!老婆体感一直不错,现在一直进行肺功能吹气训练,希望元旦手术后能尽快恢复。 肺癌这病,就算类型症状一样,大小分期一样,基因突变一样,免疫表达一样,用药一样,效果也因人而异。除了用药外,病人的身体状况、精神状态、营养铺助、运动训练,都与你的预后有关。希望我老婆的治疗过程能给病友们带来一点点帮助。另外,推荐便秘的病友一定试试益生菌粉,效果真的不错,有研究说对免疫治疗也有积极促进作用。

收藏
回复(13)举报
参与评论
评论列表
按投票顺序
祝手术顺利!
举报
2021-12-30 23:25:55 有用(1)
回复(0)
祝手术顺利
举报
2021-12-30 10:13:44 有用(0)
回复(0)
敏感的红豆7603接好运 希望我爸爸也有这样的运气 可以手术
举报
2022-03-04 16:58:13 有用(0)
回复(1)
觅友_66999祝手术顺利
举报
2021-12-30 17:15:53 有用(0)
回复(0)
淡淡的柿子 云山加油,我们在附一,我们副作用明显,白细胞,血小板降的多,神经反应也大。
举报
2021-12-30 17:35:06 有用(0)
回复(0)
治疗效果太好了!!!!
举报
2021-12-31 09:00:52 有用(0)
回复(0)
加油
举报
2021-12-30 12:55:11 有用(0)
回复(0)
K药是指免疫治疗吗?联合化疗?
举报
2022-01-02 07:10:47 有用(0)
回复(1)
爸爸有免疫表达,也有靶点,医生建议先吃靶向药,不知道该怎么选择
举报
2022-01-02 07:11:43 有用(0)
回复(1)
震动的铁链我们也准备用k药
举报
2021-12-31 14:15:44 有用(0)
回复(0)
相关推荐
热点推荐
2013-11-19 14:23:04
爸爸确诊病情已经有11个多月了。一共做了8次大化疗,2次小化疗,以及35次放疗,上月返医院检查“瘤子”没有了。这一路走来,有多少的艰辛与泪水。在这里与大家分享爸爸的治疗过程。起初,拿到病例报告的时候,
2013-11-19 14:31:01
妈妈患肺癌已经有三年了,这三年来一直在接受治疗到现在,下面是妈妈检查以及治疗的过程。2010年10月,妈妈体检出肺癌IV期,纵隔淋巴转移,肝部转移,去省肿瘤医院复查,做了PET-CT,结果一样,省肿瘤
2013-11-19 15:04:43
2011年11月,妈妈被诊断肺癌,我在网上浏览了很多帖子,学到了很多,看到了一批又一批共同奋斗在抗癌战线上的战友。这15个月走下来,越来越体会到抗癌之路的艰辛,今天发个帖子,记录一下妈妈的治疗经过,也






